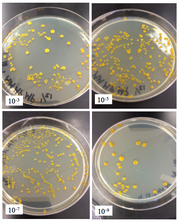
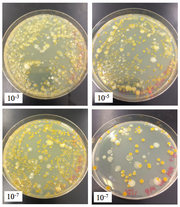

Uploads by Mary L. Pavia
From OpenWetWare
Jump to navigationJump to search
This special page shows all uploaded files.
| Date | Name | Thumbnail | Size | Description |
|---|---|---|---|---|
| 22:01, 8 March 2015 | Fixed Specimen Day 8.png (file) |  |
70 KB | |
| 02:00, 3 March 2015 | IndivTest Day 10.png (file) |  |
328 KB | |
| 02:00, 3 March 2015 | IndivControl Day 10.png (file) |  |
332 KB | |
| 01:59, 3 March 2015 | Control Day 8.png (file) |  |
237 KB | |
| 01:59, 3 March 2015 | Test Day 8.png (file) |  |
290 KB | |
| 01:21, 23 February 2015 | Day 2.png (file) |  |
90 KB | |
| 01:20, 23 February 2015 | Day 1.png (file) |  |
81 KB | |
| 05:37, 19 February 2015 | Screen Shot 2015-02-19 at 12.36.51 AM.png (file) |  |
62 KB | |
| 15:33, 18 February 2015 | Invertebrate Table.png (file) |  |
45 KB | |
| 21:38, 10 February 2015 | Mushroom Picture.png (file) |  |
659 KB | |
| 21:37, 10 February 2015 | Results from PCR.png (file) |  |
591 KB | |
| 21:37, 10 February 2015 | PCR Results.jpeg (file) |  |
1.84 MB | |
| 21:32, 10 February 2015 | Descriptive Table about Plantae and Fungi.png (file) |  |
90 KB | |
| 06:18, 7 February 2015 | Clover Weed Plant.png (file) |  |
472 KB | |
| 06:18, 7 February 2015 | Mushroom Fungi.png (file) |  |
340 KB | |
| 06:17, 7 February 2015 | Kale Plant.png (file) |  |
457 KB | |
| 06:17, 7 February 2015 | Bristled Weed Plant.png (file) |  |
495 KB | |
| 06:17, 7 February 2015 | Brussels Sprout Plant.png (file) |  |
508 KB | |
| 04:08, 4 February 2015 | NA + Tet Plates.png (file) | |
393 KB | |
| 04:00, 4 February 2015 | NA Plates.png (file) | |
469 KB | |
| 03:24, 4 February 2015 | Serial Dilution Results.png (file) |  |
46 KB | |
| 02:37, 4 February 2015 | Transect Week 2.png (file) |  |
652 KB | |
| 05:12, 28 January 2015 | Organism observed.JPG (file) |  |
1.27 MB | |
| 05:11, 28 January 2015 | Organism 4.jpeg (file) |  |
1.73 MB | |
| 05:11, 28 January 2015 | Organism 3.jpeg (file) |  |
1.5 MB | |
| 05:10, 28 January 2015 | Organism 2.jpeg (file) |  |
1.82 MB | |
| 05:10, 28 January 2015 | Organism 1.jpeg (file) |  |
1 MB | |
| 05:10, 28 January 2015 | Image 3 Back.jpeg (file) |  |
1.17 MB | |
| 05:09, 28 January 2015 | Image 2 Front.jpeg (file) |  |
1.28 MB | |
| 05:09, 28 January 2015 | Image 1 Top.jpeg (file) |  |
1.25 MB | |
| 05:08, 28 January 2015 | Dilution Table.png (file) |  |
52 KB | |
| 02:11, 26 January 2015 | 4. Shrubs.jpeg (file) |  |
4.96 MB | Image 4 shows the south and southeaster side of the transect, where the 5 shrubs are present. Plant matter surrounds each individual plant. |
| 02:11, 26 January 2015 | 3. Lettuce.jpeg (file) |  |
4.34 MB | Image 3 is of the lettuce planter box. The northwestern corner of the box is home to one lettuce plant. Snow is inside of the planter box as well. |
| 02:10, 26 January 2015 | 2. Kale and Cucumber.jpeg (file) |  |
4.7 MB | Image 2 depicts the kale and cucumber planter boxes. The kale planter box has over 15 sprouted kale plants and an irrigation hose is present within the box. Also, a small scarecrow is lying in the far southwestern corner of the box. In the cucumber plante |
| 02:10, 26 January 2015 | 1. Brussels Sprouts.jpeg (file) |  |
4.14 MB | Image 1 shows the Brussels sprout planter box, as well as the decomposing plant matter on top of the soil within the box. The image also displays the wood chipped pathway in between the boxes within the fenced in farm garden. |